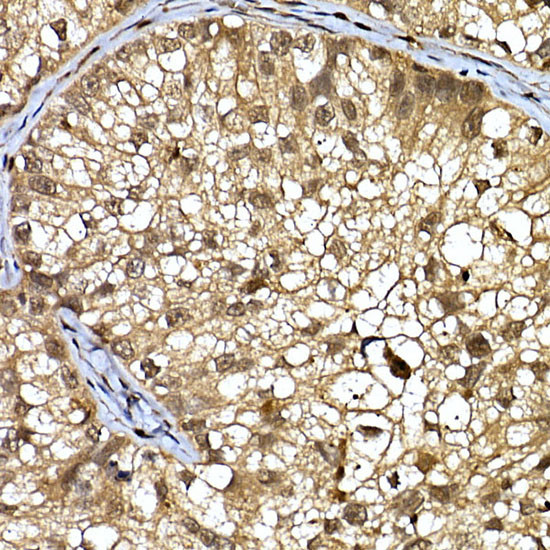
DCAF7 Antibody in Immunohistochemistry (Paraffin) (IHC (P))

Search
Invitrogen
DCAF7 Polyclonal Antibody
{{$productOrderCtrl.translations['antibody.pdp.commerceCard.promotion.promotions']}}
{{$productOrderCtrl.translations['antibody.pdp.commerceCard.promotion.viewpromo']}}
{{$productOrderCtrl.translations['antibody.pdp.commerceCard.promotion.promocode']}}: {{promo.promoCode}} {{promo.promoTitle}} {{promo.promoDescription}}. {{$productOrderCtrl.translations['antibody.pdp.commerceCard.promotion.learnmore']}}
图: 1 / 4
DCAF7 Antibody (PA5-77024) in IHC (P)




Please note: We are reviewing Western blot images included in the antibody testing data in our catalog, including those provided by third parties. Unless expressly labeled or annotated as “raw-unedited”, Western blot images included in the antibody testing data in our catalog may have been edited, optimized or otherwise adjusted for presentation.
产品信息
PA5-77024
种属反应
宿主/亚型
分类
类型
抗原
偶联物
形式
浓度
规格
纯化类型
保存液
内含物
保存条件
运输条件
RRID
产品详细信息
The antibody was affinity-purified from rabbit antiserum by affinity-chromatography using epitope-specific immunogen and the purity is > 95% (by SDS-PAGE).
靶标信息
WD-repeats are motifs that are found in a variety of proteins and are characterized by a conserved core of 40-60 amino acids that commonly form a tertiary propeller structure. While proteins that contain WD-repeats participate in a wide range of cellular functions, they are generally involved in regulatory mechanisms concerning chromatin assembly, cell cycle control, signal transduction, RNA processing, apoptosis and vesicular trafficking. WDR68 (WD repeat-containing protein 68), also known as DCAF7 (DDB1- and CUL4- associated factor 7), HAN11 or WDR68, is a 342 amino acid protein that belongs to the WD repeat DCAF7 family and contains 4 WD repeats. Localizing to the cytoplasm and nucleus, WDR68 is involved in protein modification and ubiquitination pathways, and interacts directly with Dyrk1A, Dyrk1B and Dia 1. WDR68 is involved in craniofacial development, and may be involved in skin development.
仅用于科研。不用于诊断过程。未经明确授权不得转售。
篇参考文献 (0)
生物信息学
蛋白别名: DDB1- and CUL4-associated factor 7; WD repeat domain 68; WD repeat-containing protein 68; WD repeat-containing protein An11 homolog; WD-repeat protein
基因别名: 1700012F10Rik; 2610037L01Rik; C86529; DCAF7; HAN11; RGD1305140; WDR68
UniProt ID: (Mouse) P61963
Entrez Gene ID: (Mouse) 71833, (Rat) 303602